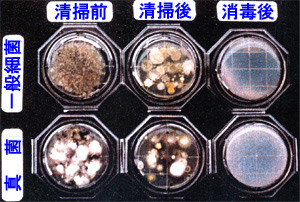
きれいに見える空調ダクト内部で細菌検査をした結果、多くの細菌が蔓延している写真

空調ダクトの清掃と消毒
空調ダクトは10年以上経過しますと、各種のアレルギー性症状の誘発、OA機器の故障や室内の空気環境汚染を招くカビや細菌微生物を含んだ塵埃が堆積しています。

▲塵埃が堆積した空調ダクト内部

▲空調ダクト内部の細菌検査
空調ダクト内部で細菌検査を行いますと、左の画像を見て頂ければおわかりいただける通り、細菌というのは清掃しただけでは無くなりません。
清掃で一見綺麗に見える空調ダクト内部にも、実はこんなにも細菌が蔓延しています。
そこで、消毒が必要になってきます。

▲空調ダクト清掃前

▲空調ダクト清掃・消毒後

▲空調ダクト消毒状況
空調ダクト清掃使用機器
| 集塵機仕様 |
ダクリン・コレクター2台(吸引部 DEM-110型・集塵部 DF-220型) 風量 6600CMH 静圧 300mmAq |
| コンプレッサー仕様 | 北越工業/PDS-90S(25馬力) |
| トリートメント剤仕様 |
商品名 ヒビテン・クルコネート液 製造会社 住友製薬株式会社 昭和34年9月22日承認 812619号 |

